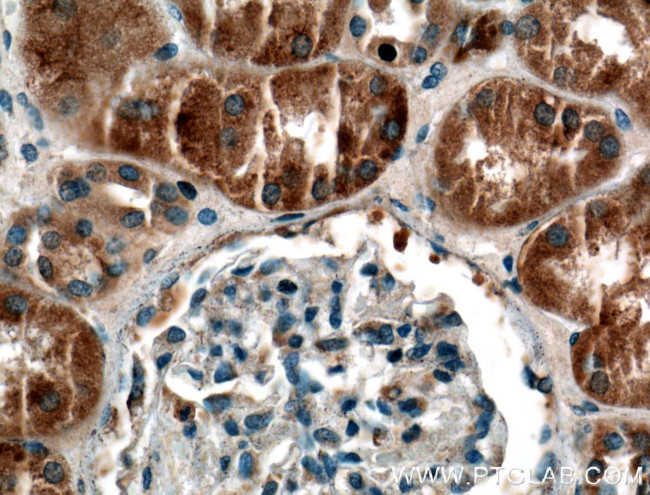
SYTL3 Antibody in Immunohistochemistry (Paraffin) (IHC (P))

Search
Proteintech
SYTL3 Polyclonal Antibody
{{$productOrderCtrl.translations['antibody.pdp.commerceCard.promotion.promotions']}}
{{$productOrderCtrl.translations['antibody.pdp.commerceCard.promotion.viewpromo']}}
{{$productOrderCtrl.translations['antibody.pdp.commerceCard.promotion.promocode']}}: {{promo.promoCode}} {{promo.promoTitle}} {{promo.promoDescription}}. {{$productOrderCtrl.translations['antibody.pdp.commerceCard.promotion.learnmore']}}
产品信息
22076-1-AP
种属反应
宿主/亚型
分类
类型
抗原
偶联物
形式
浓度
规格
纯化类型
保存液
内含物
保存条件
运输条件
产品详细信息
Immunogen sequence: DNANVTGEI EFAIHYCFKT HSLEICIKAC KNLAYGEEKK KKCNPYVKTY LLPDRSSQGK RKTGVQRNTV DPTFQETLKY QVAPAQLVTR QLQVSVWHLG TLARRVFLGE VIIPLATWDF EDSTTQSFRW HPLRAKAEKY EDSVPQSNGE LTVRAKLVLP SRPRKLQEAQ EGTDQPSLHG QLCLVVLGAK NLPVRPDGTL NSFVKGCLTL PDQQKLRLKS PVLRKQACPQ WKHSFVFSGV TPAQLRQSSL ELTVWDQALF GMNDRLLGGT RLGSKGDTAV GGDACSQSKL QWQKVLSSPN LWTDMTLVLH (302-610 aa encoded by BC100830)
靶标信息
May act as Rab effector protein and play a role in vesicle trafficking. Binds phospholipids in the presence of calcium ions.
仅用于科研。不用于诊断过程。未经明确授权不得转售。
生物信息学
蛋白别名: Exophilin-6; Synaptotagmin-like protein 3; unnamed protein product
基因别名: A430092N21; mFLJ00307; RGD1561992; SLP3; Slp3-a; Slp3-b; SYTL3
UniProt ID: (Human) Q4VX76, (Mouse) Q99N48
Entrez Gene ID: (Human) 94120, (Mouse) 83672, (Rat) 499017